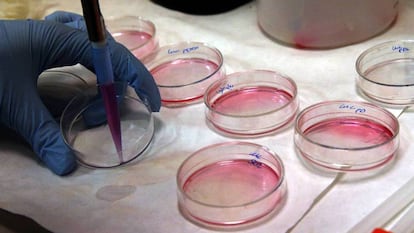

Una terapia génica revierte la diabetes tipo II y la obesidad en ratones
Investigadores de la UAB logran que un gen terapéutico llegue al hígado, al tejido adiposo o al músculo esquelético y exprese una proteína que trata la resistencia a la insulina

La terapia génica ha cogido carrerilla; desde la revolucionaria técnica CRISPR de edición genética hasta la llegada al mercado de los primeros tratamientos para tratar leucemias sin alternativa terapéutica a través de la técnica CAR-T, por la que se manipulan en el laboratorio los linfocitos T del paciente. En los últimos años, la ingeniería genética se ha abierto paso en la investigación biomédica en una carrera de fondo por corregir genes defectuosos y fallos orgánicos que provocan enfermedades. Entre los últimos en probar la eficacia de la terapia génica en ratones se encuentra un grupo de investigadores de la Universidad Autónoma de Barcelona (UAB), que ha logrado revertir la diabetes tipo II y la obesidad de estos animales.
Los científicos han empleado un vector viral al que han eliminado toda su carga patógena y colocado, en su lugar, el gen terapéutico que querían hacer llegar al organismo para regular la actividad metabólica. A través de una sola inyección, ese virus se dirigió al hígado e infectó sus células con el gen terapéutico para que el órgano secretase por sí mismo esa proteína que controla el metabolismo. Con este sistema, los investigadores lograron regular la resistencia a la insulina y eliminar la diabetes de los ratones.
Los investigadores pusieron el foco en una proteína, la FGF21, que secreta el propio organismo para regular la actividad metabólica. Esta hormona se segrega de forma natural por diversos órganos, especialmente el hígado, y sirve para controlar los niveles de glucosa y grasa y mantener un funcionamiento energético correcto. "En la diabetes intervienen muchos genes y factores ambientales. A diferencia de las enfermedades raras, no tenemos un gen para ir y arreglarlo. Tenemos que conocer los mecanismos moleculares que intervienen y encontrar factores que podrían funcionar. Y pensamos que la FGF21 era un buen candidato. Nosotros pensamos que podría ser interesante producir la proteína natural, pero usar los vectores de terapia génica, manipular tejidos para que produzcan esa proteína", explica la investigadora de la UAB y autora del estudio, Fàtima Bosch.
Ya había antecedentes que exploraban el uso de la FGF21 para tratar la diabetes. "Hay estudios con animales donde se introducía la proteína nativa pero tiene una vida muy corta y se necesitaría inyectar cada día", apunta la científica. También la industria farmacéutica diseñó análogos de la FGF21, "pero son proteínas sintéticas y a veces el organismo no las reconoce", matiza Bosch. Así, con una dolencia como la diabetes, que ya es considerada una epidemia mundial (425 millones de personas la padecen en el mundo) y su tratamiento depende, en buena medida, de la adherencia del paciente a la terapia, los investigadores de la UAB optaron por intentar producir la proteína natural, pero manipular genéticamente los tejidos donde se secretan para que produzcan esta hormona.
Así, los científicos probaron este sistema en hígado, tejido adiposo y músculo esquelético. Se trataba de un vector viral, que funcionaba a modo de vehículo, para transportar el gen terapéutico que expresa la proteína FGF21. "Este vector deriva de un virus que no causa patología, pero puede infectar cualquier tipo de tejido y puede durar mucho tiempo. Nosotros probamos el vector que porta el FGF21 en tres tejidos y en todos los casos se puede sintetizar la proteína, que luego se distribuye por la sangre, y puede aguantar durante mucho tiempo", apunta Bosch.
Esta terapia también ha demostrado un efecto protector contra el riesgo de desarrollar tumores hepáticos
Estos virus manipulados genéticamente no se replican ni tienen capacidad patógena. En el laboratorio se vacían de su contenido nocivo e infeccioso y se les deja solamente su capacidad para introducirse en el núcleo de las células. Los científicos lo aprovechan como una especie de mensajero: en lugar de su carga patógena, los investigadores le incorporan el gen que expresa la proteína que desean instalar en el organismo (en este caso la FGF21) y lo usan como vehículo para que llegue a las células y las infecte con ese gen terapéutico. Cuando las células de ese tejido consiguen secretar por sí mismas la proteína, ésta se envía al torrente sanguíneo, que la distribuye por todo el cuerpo.
El equipo de Bosch probó esta terapia en modelos de ratones con diabetes tipo II y obesidad -tanto inducida genéticamente como a través de una dieta rica en lípidos-. Primero, lo probaron aplicando una sola inyección del factor terapéutico en el hígado y los resultados no tardaron en llegar. "Los animales normalizaban los índices de insulina. Se reducía la resistencia a la insulina, eran más sensibles. Y en los animales que ya son obesos genéticamente, con el tratamiento en dos dosis diferentes, revertimos el incremento de peso. Les bajaba la insulinemia y normalizaban los niveles de glucosa circulante", explica Bosch.
Los investigadores hicieron el mismo experimento en tejido adiposo y músculo esquelético y se hizo un seguimiento de los animales durante un año y medio. "Los ratones han disminuido de peso y se ha reducido la acumulación de grasa y la inflamación en el tejido adiposo. Además, se ha contrarrestado el depósito de grasas, la inflamación y la fibrosis en el hígado, ha aumentado la sensibilidad a la salud general y no se han observado efectos secundarios", constata la investigadora de la UAB, que ha publicado su estudio en la revista científica EMBO Molecular Medicine. Esta terapia también ha demostrado un efecto protector contra el riesgo de desarrollar tumores hepáticos (puede ocurrir cuando este órgano está sometido a una dieta hipercalórica durante mucho tiempo).
Bosch considera que el hallazgo abre la puerta a nuevos tratamientos para este tipo de dolencias. "Es la primera vez que se logra contrarrestar la obesidad y la resistencia a la insulina a largo plazo mediante la administración de una sola sesión de terapia génica en modelo animal", apunta. Sin embargo, aclara, tardará en traducirse esta investigación en la práctica clinica. De hecho, el siguiente paso es probar esta terapia con animales más grandes y luego, si funciona, comenzar los ensayos clínicos con pacientes.
Tu suscripción se está usando en otro dispositivo
¿Quieres añadir otro usuario a tu suscripción?
Si continúas leyendo en este dispositivo, no se podrá leer en el otro.
FlechaTu suscripción se está usando en otro dispositivo y solo puedes acceder a EL PAÍS desde un dispositivo a la vez.
Si quieres compartir tu cuenta, cambia tu suscripción a la modalidad Premium, así podrás añadir otro usuario. Cada uno accederá con su propia cuenta de email, lo que os permitirá personalizar vuestra experiencia en EL PAÍS.
¿Tienes una suscripción de empresa? Accede aquí para contratar más cuentas.
En el caso de no saber quién está usando tu cuenta, te recomendamos cambiar tu contraseña aquí.
Si decides continuar compartiendo tu cuenta, este mensaje se mostrará en tu dispositivo y en el de la otra persona que está usando tu cuenta de forma indefinida, afectando a tu experiencia de lectura. Puedes consultar aquí los términos y condiciones de la suscripción digital.
Archivado En
- Terapia génica
- Obesidad
- Medicina regenerativa
- Ingenieria genética
- UAB
- Diabetes
- Bioingeniería
- Enfermedades endocrinas
- Enfermedades genéticas
- Ingeniería
- Tratamiento médico
- Universidad
- Educación superior
- Enfermedades
- Especialidades médicas
- Sistema educativo
- Medicina
- Educación
- Genética
- Salud
- Industria
- Biología
- Ciencias naturales
- Ciencia


























































